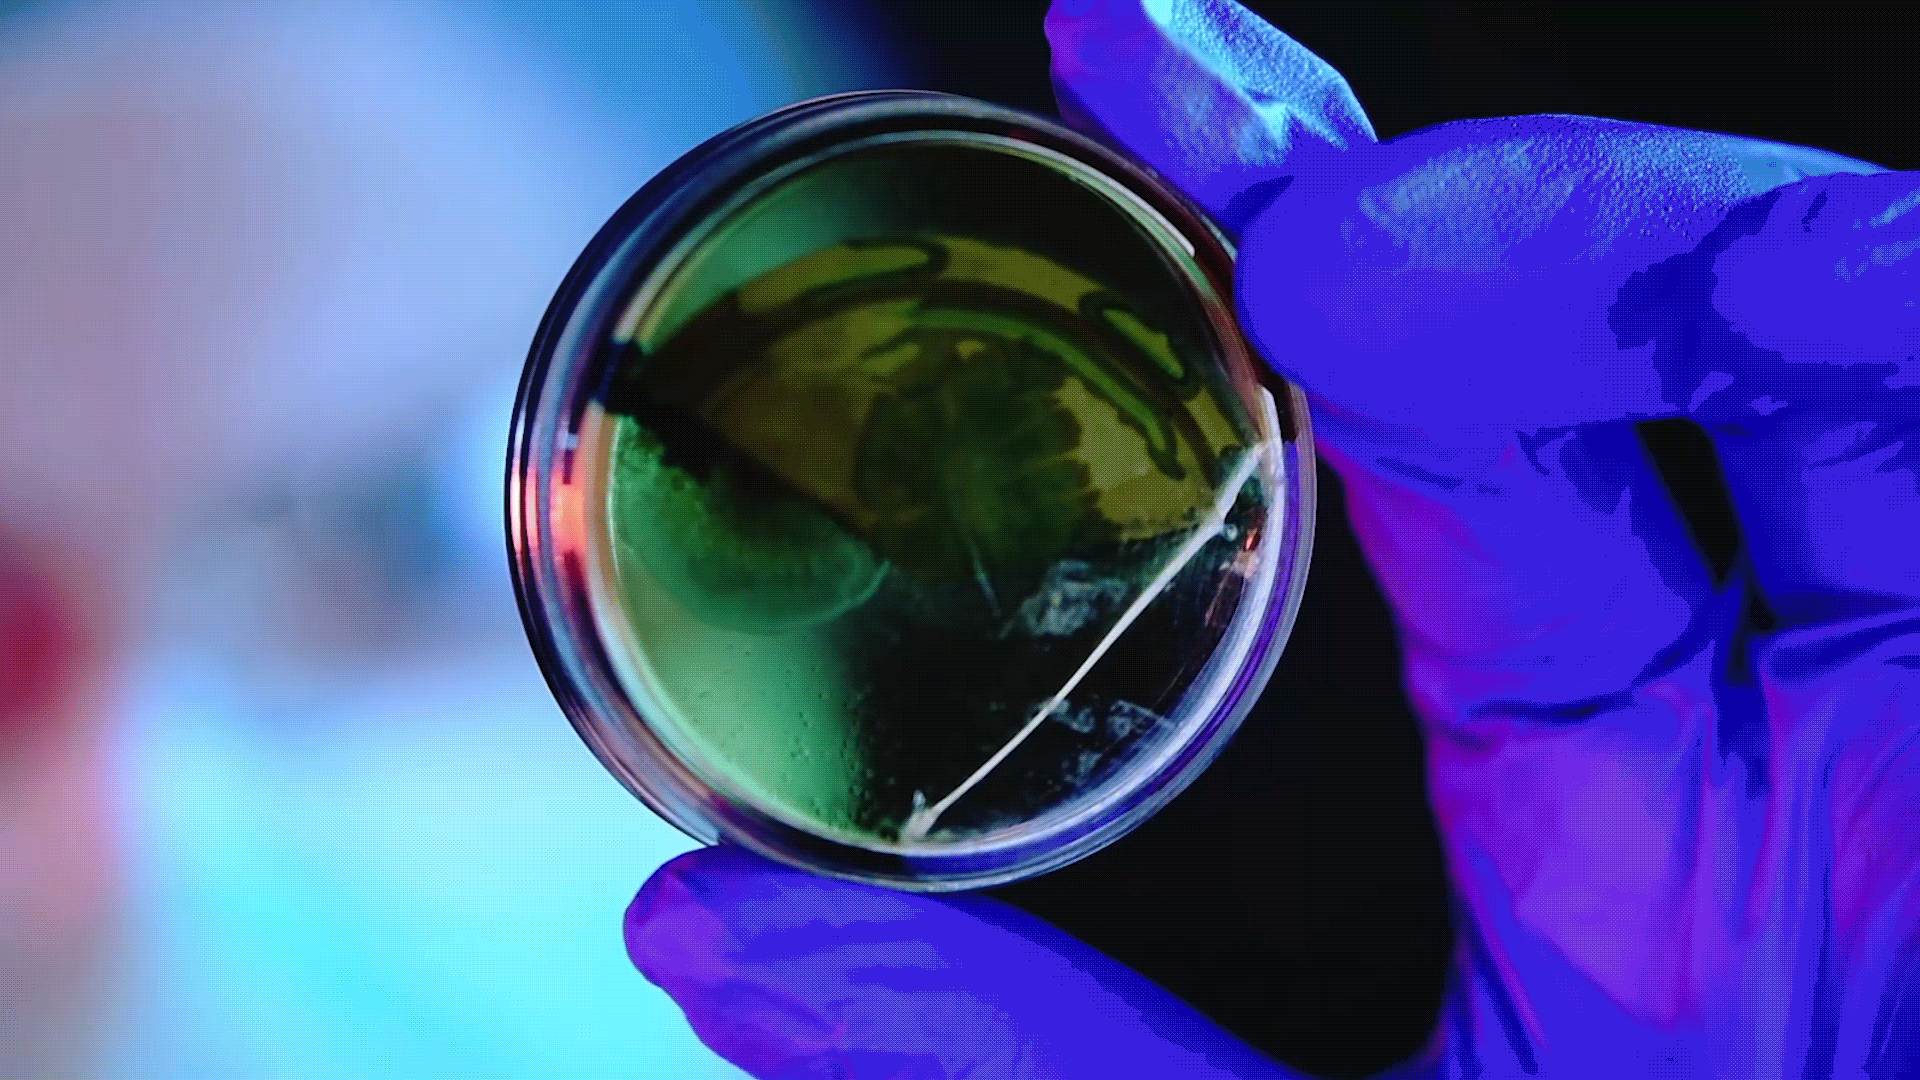

Tree Top Director: Tibor Nemeth
Bristol Myers Squibb Director: Tibor Nemeth
Duke University Director: Tibor Nemeth
Kioti Tractors Director: Tibor Nemeth
Seventh Generation Director: Cynthia Wade
Wyman's of Maine Director: Tibor Nemeth
Meineke Director: Charles Wittenmeier
Mommy Wars Similac Director: Cynthia Wade
Mommy Wars Maternity Leave Director: Cynthia Wade
MassMutual Love is a Gift Director: Tibor Nemeth
IBM Dispatches from a Small Planet- Japan Director: Doug Pray
IBM Dispatches from a Small Planet-China Director: Doug Pray
IBM Dispatches from a Small Planet-China Director: Doug Pray
IBM Dispatches from a Small Planet- Japan Director: Doug Pray
Dunkin What Are You Drinkin' Director: Marc Colucci